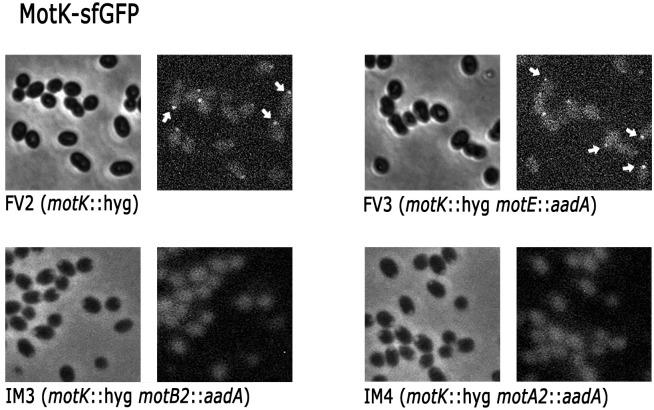
https://cdn.ncbi.nlm.nih.gov/pmc/blobs/23ec/10954123/d18e9445ec3c/pone.0298028.g011.jpg

球形红杆菌 Fla2 鞭毛的旋转需要周质蛋白 MotK 和 MotE,它们与鞭毛定子蛋白 MotB2 相互作用。
Rotation of the Fla2 flagella of Cereibacter sphaeroides requires the periplasmic proteins MotK and MotE that interact with the flagellar stator protein MotB2.
机构信息
Instituto de Investigaciones Biomédicas, Universidad Nacional Autónoma de México, Mexico City, Mexico.
Instituto de Fisiología Celular, Universidad Nacional Autónoma de México, Mexico City, Mexico.
出版信息
PLoS One. 2024 Mar 20;19(3):e0298028. doi: 10.1371/journal.pone.0298028. eCollection 2024.
The bacterial flagellum is a complex structure formed by more than 25 different proteins, this appendage comprises three conserved structures: the basal body, the hook and filament. The basal body, embedded in the cell envelope, is the most complex structure and houses the export apparatus and the motor. In situ images of the flagellar motor in different species have revealed a huge diversity of structures that surround the well-conserved periplasmic components of the basal body. The identity of the proteins that form these novel structures in many cases has been elucidated genetically and biochemically, but in others they remain to be identified or characterized. In this work, we report that in the alpha proteobacteria Cereibacter sphaeroides the novel protein MotK along with MotE are essential for flagellar rotation. We show evidence that these periplasmic proteins interact with each other and with MotB2. Moreover, these proteins localize to the flagellated pole and MotK localization is dependent on MotB2 and MotA2. These results together suggest that the role of MotK and MotE is to activate or recruit the flagellar stators to the flagellar structure.
细菌鞭毛是一种由超过 25 种不同蛋白质组成的复杂结构,这个附属物包含三个保守结构:基体、钩和鞭毛丝。基体,嵌入在细胞膜中,是最复杂的结构,容纳着出口装置和发动机。在不同物种的鞭毛发动机的原位图像中,揭示了围绕基体周质成分的高度多样化的结构。在许多情况下,形成这些新结构的蛋白质的身份已经通过遗传和生化方法得到了阐明,但在其他情况下,它们仍然需要被鉴定或表征。在这项工作中,我们报告了在α变形菌鞘氨醇单胞菌中,新的蛋白质 MotK 连同 MotE 对于鞭毛的旋转是必不可少的。我们有证据表明,这些周质蛋白相互作用,并与 MotB2 相互作用。此外,这些蛋白质定位于鞭毛极点,并且 MotK 的定位依赖于 MotB2 和 MotA2。这些结果共同表明,MotK 和 MotE 的作用是激活或招募鞭毛定子到鞭毛结构。